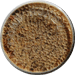

|

|

|
|
Elmore's Honey Products |
|
All honey has somewhat subtle flavoring that is determined by what the bees are feeding on, the location of the hives and the time of year. Products are available in Blackberry, Orange Blossom, White Clover, Star Thistle and Wild Flower. For more information on how honey gets subtle variations in flavor, visit our Honey Facts page.
|
|
Honey Products |
|||
|
|

|
|
|
|
Honey Bears |
Queenline Honey |
Honey Quarts |
|
|
12 oz - $4.00 |
1 lb - $5.00 |
1-1/2
lb $6.00 |
|
|
Royal Jelly Products |
||

|

|
|
|
Pure Royal Jelly |
Royal Jelly/Honey Blend |
|
|
12 oz - $10.00 |
12 oz - $10.00 |
|
Check out |
| Elmore's Honey |
Site maintained by InternetWebBuilders.Com. |